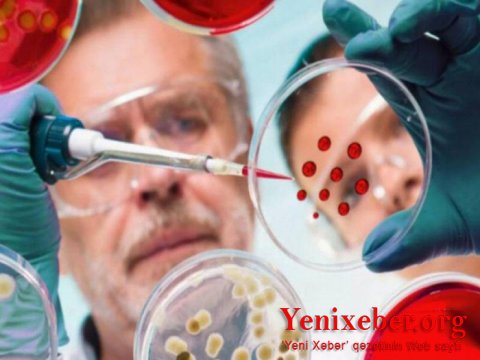
Bu ölkədə koronavirusun yeni ştammı aşkarlandı

"Hindistan ştammı" bu ölkəyə də çatdı

Slovakiyada koronavirusun mutasiya olmuş növü olan "Delta"ya ("Hindistan ştammı" - red.) ilk yoluxma halı qeydə alınıb.
Yenixeber.org: Bu barədə ölkənin Səhiyyə Nazirliyi "Facebook"da məlumat yayıb.
Qeyd edilir ki, xəstə Rusiyadan gəlib. O Avropa çempionatının futbol oyunlarına getməyib və insanlarla yaxın təmasda olmayıb. Yeni mutasiyalı virusa yoluxmuş şəxsi hazırda xüsusi təcrid vəziyyətində saxlayırlar.
Səhiyyə Nazirliyi xatırlatma edib ki, "Hindistan ştammı" koronavirusun ən yoluxucu və təhlükəli mutasiyasından biridir.
Qeyd edilir ki, xəstə Rusiyadan gəlib. O Avropa çempionatının futbol oyunlarına getməyib və insanlarla yaxın təmasda olmayıb. Yeni mutasiyalı virusa yoluxmuş şəxsi hazırda xüsusi təcrid vəziyyətində saxlayırlar.
Səhiyyə Nazirliyi xatırlatma edib ki, "Hindistan ştammı" koronavirusun ən yoluxucu və təhlükəli mutasiyasından biridir.









 AZ
AZ RU
RU